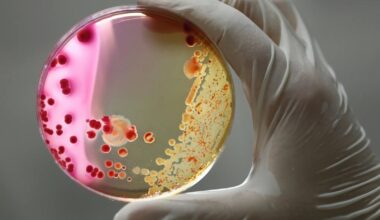
Bacteriile devin tot mai puternice, iar antibioticele tot mai slabe. Una din șase infecții bacteriene este rezistentă la tratament

Medicamentul care ar putea elimina una dintre cele mai mari amenințări la adresa sănătății umane. Cercetătorii au descoperit un compus de o sută de ori mai eficient
Sambata, 01 Noiembrie 2025, ora 09:41 2579 citiri Un nou antibiotic ar putea distruge bacteriile multirezistente FOTO Pexels…